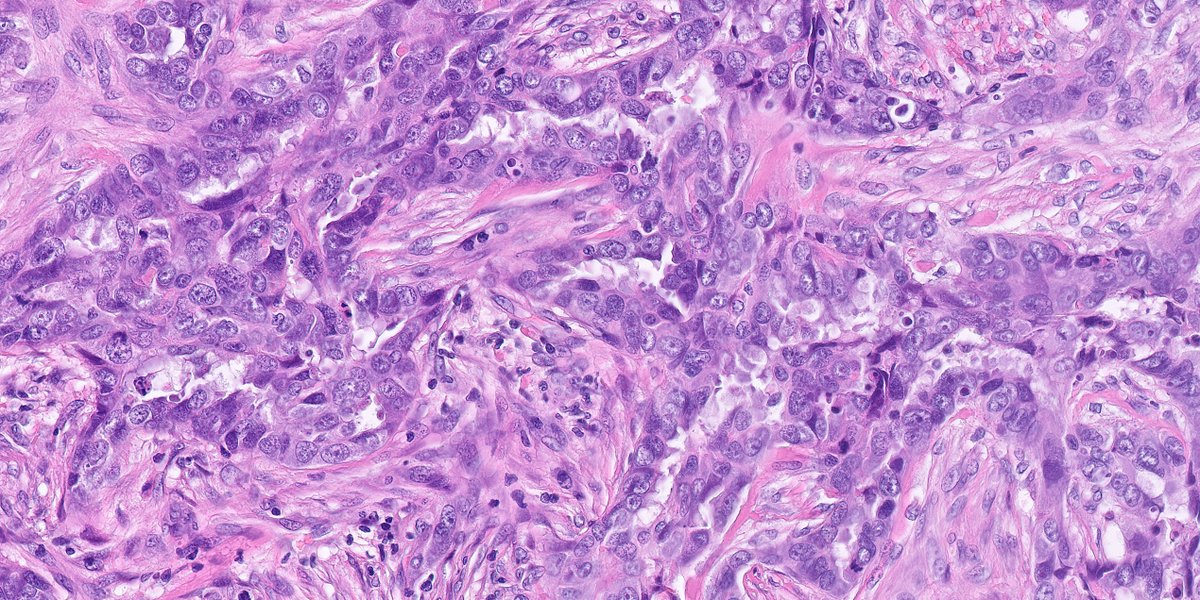
1/ #breastpath lovers, have you heard about this new entity of "serous carcinoma-like" breast carcinoma? 😉
#pathology #IHCpath- the IHCs showed negativity for ER, PR, HER2, GATA3, Sox10

Med Amine
@essaoudimohamed
pathologist
ID: 1612739461
22-07-2013 12:18:02
5,5K Tweet
835 Followers
653 Following









F, 40s, breast nodule. Dr. Luca Olaleke Folaranmi Fouad Boulos Raza Hoda MD Alexander Damron, MD Brian McMillen MD Liza Quintana, MD Tania Labiano Aurélien Morini, MD, MSc 🇫🇷🇪🇺💙💛 Celina Stayerman MD Nusrat Z. Bokhari Amal Asar, FRCPath, MAcadMED Tristan Rutland MBBS FRCPA IFCAP Israh Akhtar Khan Lorand Kis Padma Priya J Barry McGinn Pascual Meseguer Med Amine, MD 🔬 Kalyani Bambal #breastpath


Soft tissue, abdominal wall, debridement: Hx: Non healing wound. This is what you see. How would you sign it out? What stains would you order? #PathX #pathquiz Michigan Pathology





71 y.o. F. What is your diagnosis? More photos in chat. #PathTwitter Mass General Brigham Pathology MGH Pathology






I can't really explain why it looks so much like Sevelamer. According to this paper by Michael Arnold, MD, PhD, BASs should be homogeneous. pubmed.ncbi.nlm.nih.gov/24921636/ However, it does say that it can show fracture lines which may resemble fishscales. 👇